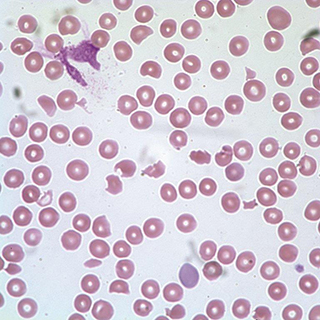

Most common cause of health-care related diarrhea
Clostridium difficile
Most common scoring system used to assess the probability of heparin-induced thrombocytopenia
4T's score
Nonpharmacologic therapy for all patients with fibromyalgia
Regular aerobic exercise
pathophysiologic mechanism of systemic hypotension in a mechanically-ventilated COPD patient with incomplete exhalation
Auto–positive end-expiratory pressure (accept auto-PEEP; dynamic hyperinflation)
Statistical term for estimation of the probability of disease before testing
Pretest probability
Empiric 2-drug antibiotic therapy for patient with this CSF gram-stain
Vancomycin and 3rd generation cephalosporin (e.g., cefotaxime, ceftriaxone)
Diagnosis for Hgb 5.5 gm/dL with 0.1% reticulocytes and normal platelet count, leukocyte count, and bilirubin
Pure red cell aplasia
Long-term complication of meniscectomy
Early-onset knee osteoarthritis (accept osteoarthritis)
pulmonary complication associated with rapid removal of a large volume of pleural fluid
Reexpansion pulmonary edema (accept pulmonary edema)
The inverse of this measure is used to calculate the number needed to treat (NNT)
Absolute risk reduction
Definition of multidrug-resistant tuberculosis
Resistant to at least isoniazid and rifampin
Diagnosis for splanchnic thrombosis, pancytopenia, and non-immune hemolytic anemia
Paroxysmal nocturnal hemoglobinuria
An immune-mediated condition that causes external ear inflammation sparing the earlobe
Relapsing polychondritis
Antidote for methanol poisoning
Fomepizole (accept ethanol)
A negative likelihood ratio of 0.2 decreases the probability of disease by approximately this amount
30% (accept 0.30)
Infection associated with properdin deficiency
Neisseria infection (accept either Neisseria meningitis or gonorrhea)
Underlying diagnosis responsible for this peripheral blood smear following treatment with nitrofurantoin
G6PD deficiency
Most commonly reported spinal movement limitation associated with idiopathic skeletal hyperostosis
Limited motion of the thoracic spine
Term for marked hypertension with acute kidney injury, hematuria, and proteinuria
Malignant nephrosclerosis (accept acute hypertensive nephrosclerosis)
Arithmetic operation used to combine 2 likelihood ratios of 2 independent findings for a disease
Multiply
Condition associated with this rash is transmitted by the Lone Star tick
Southern tick-associated rash illness (STARI)
Agent that reverses dabigatran anticoagulant effect
Idarucizumab (accept Praxbind)
Common medical name for localized scleroderma otherwise described as 'en coup de sabre'
Linear scleroderma
Syndrome of hyperthermia and hyperreflexia and clonus
Serotonin syndrome
Case-control study variant that uses a specified number of control patients for analysis of each case
Nested case-control study